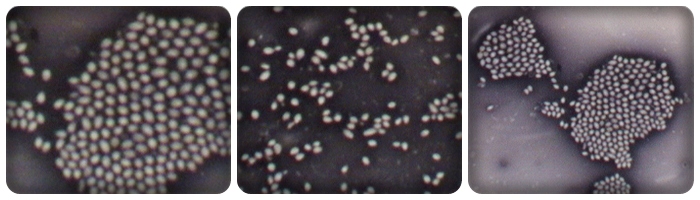

|
|
Regne de les moneres.

Arran de la
descoberta del microscopi, es varen descriure molts organismes, massa petits
perquč s'haguessin pogut trobar abans. Al principi, tots es varen anomenar
genčricament microorganismes o microbis.
Més tard, es
va veure que alguns tenien característiques semblants
als vegetals, com ara tenir clorofil.la i ser immňbils, i d'altres
s'assemblaven més als animals, ja que no tenien clorofil.la i es movien,
capturant altres microorganismes.
Altres no
presentaven característiques semblants a animals ni a vegetals.
Amb el temps,
s'ha arribat a un criteri molt generalitzat, que és el d'incloure tots els
microorganismes unicel.lulars i sense vertader nucli en
el regne de les moneres, i la resta, en el regne dels protists.
El regne
de les moneres és molt ric en espčcies, ja que se'n coneixen unes 3.000
aproximadament. Les principals característiques dels organismes d'aquest regne
són no tenir nucli aďllat per una membrana.
Tenen ŕcid desoxirribonucleic com a suport de la seva informació genčtica, perň
aquest es troba aďllat a una zona de la cčl.lula
i sense cap embolcall. Tampoc no tenen cap orgŕnul membranós, és a dir, no
presenten reticle endoplasmŕtic, aparell de Golgi, vacúols, lisosomes, mitocondris ni cloroplasts, encara
que alguns són fotosintčtics i tenen clorofil.la. Tenen, perň, ribosomes, encara que diferents d'altres cčl.lules. Aquesta organització cel.lular s'anomena procariota.
Una teoria molt acceptada és que els mitocondris i els
cloroplasts de les cčl.lules eucariotes, és a
dir, amb nucli i orgŕnuls, provenen de microorganismes procariotes
simbiňtics que vivien a l'interior d'algunes cčl.lules, obtenint
totes dues un profit. Amb el temps, aquesta simbiosi es va convertir en un fet
indissoluble, i els primitius microorganismes varen esdevenir els orgŕnuls que
coneixem. El fet que mitocondris i cloroplasts presentin ADN per la síntesi
d'algunes prote‹nes al seu interior dóna suport a aquesta hipňtesi. Al
regne de les moneres es fan dues divisions: els bacteris i els cianňfits o
algues blaves.
.Els bacteris:
Els bacteris són cel.lules amb una estructura
molt senzilla. Segons la seva forma, es diuen de diferents maneres. Així si
tenen forma esfčrica es diuen cocos, si és allargada, bacils, si tenen forma de
coma, vibrions i si formen una espiral, espirils. Els bacteris, de
la mateixa manera que els éssers vius, respiren, es nodreixen i es
reprodueixen. Pel que fa a la respiració, els bacteris poden esser aerobis, si
els cal oxigen, i anaerobis, si únicament viuen en llocs sense oxigen. Es pot
donar el cas de bacteris que poden viure tant en llocs amb oxigen com sense.
Els bacteris que obtenen l'aliment per si mateixos, partint de
substŕncies no orgŕniques, es diuen autňtrofs; els
que s'alimenten dels altres éssers vius es diuen heterňtrofs: saprňfits
si l'ésser viu del qual s'alimenten és mort, i simbiňtics si
viuen sobre animals o plantes donant a canvi qualque benefici. Finalment hi ha
els parŕsits que provoquen malalties.
La reproducció
dels bacteris es fa quasi sempre per divisió. Una característica
dels bacteris és que si les condicions ambientals no són favorables no moren,
sinó que es tanquen formant espores. Ja
hem dit que una espora és un bacteri que intenta sobreviure encondicions
ambientals no adequades; de tots és sabut que bullint el material quirúrgic
podem evitar infeccions produďdes per bacteris.
Aquesta circumstŕncia es dóna ja que molt pocs bacteris poden sobreviure
més d'uns minuts a una temperatura de 100 şC.
Quasi tot
tipus de matčria orgŕnica pot servir com a aliment dels bacteris. En trobam al
petroli i a l'interior de l'aparell digestiu. En la fabricació del
vi intervenen uns bacteris anomenats sacaromices que normalment es troben a la
pellofa del raďm. Aquest bacteri absorbeix el
sucre i el descompon en alcohol eliminant diňxid de carboni. Aquest
procés rep el nom de fermentació. Un altre exemple són els bacteris que
transformen la llet en iogurt així com els que intervenen en l'elaboració
d'alguns formatges.
No hem
d'oblidar els bacteris que descomponen les restes de plantes i d'animals morts;
aquest fet del tot beneficiós permet renovar la matčria orgŕnica i fer-la de
nou utilitzable. L'adobament dels camps aprofita aquest fet, ja que
se n'alimenten nombrosos bacteris, augmentant així les substŕncies inorgŕniques
del sňl.
Els bacteris
són el grup més nombrós de les moneres. La seva estructura és més senzilla que
la de les cčl.lules eucariotes, com ja hem vist a la
introducció. L'ADN sol tenir forma anul.lar. A l'interior del bacteri la membrana fa uns replecs anomenats mesosomes
on es produeixen les reaccions que a altres cčl.lules tenen lloc a
orgŕnuls específics. Els bacteris presenten una paret cel.lular
rígida semblant a la de les cčl.lules vegetals,
que pot estar envoltada per una capa gelatinosa. Un
important mčtode de distinció, la tenyida de Gram, es basa en la naturalesa d'aquesta capa i ha servit per a
diferenciar dos grans grups, els Gram +(es tenyeixen amb aquest mčtode) i els
Gram -, que no ho fan. Els bacteris es reprodueixen per bipartició,
i quan les condicions són favorables ho fan
d'una manera molt rŕpida.
També poden
enquistar-se formant espores resistents, que
suporten llargs períodes desfavorables. Quan s'ha
d'esterilitzar algun producte, és vital tenir aixň en compte i
assegurar-nos que tant els bacteris com les seves espores són eliminats.
Els bacteris
es poden trobar a tots els ambients: aire, aigua i terra. Viuen de maneres molt
diverses, ja que en trobam de fotosintčtics, de quimiosintčtics (treuen
l'energia per elaborar el seu aliment de reaccions químiques), i altres que es
nodreixen de matčria orgŕnica ja fabricada per altres organismes, és a dir,
heterňtrofs Alguns fan servir l'oxigen, és a dir són aerňbics, i
d'altres no. Els anomenam anaerňbics. Els bacteris poden ser
parŕsits i ocasionar malalties als animals o als
vegetals, perň no tots són perjudicials. De fet, s'han utilitzat des de l'inici de la histňria per a produir
aliments com el formatge, el iogurt i altres derivats de la llet, com la
mantega, el quefir,..., el vinagre, la maceració de les fibres de cotó, etc.
Actualment les aplicacions són múltiples, des de la producció de
substŕncies com metŕ (gas combustible) o
alcohol, fins al seu ús en enginyeria genčtica, passant per l'obtenció
d'antibiňtics,... La llista seria interminable! També són importants com a
descomponedors de la matčria orgŕnica a la natura, o com a organismes
simbiňtics en el cas d'alguns vegetals, que s'hi associen per a poder
fabricar substŕncies que tot sols no podrien sintetitzar.
Els cianňfits:
Algues verd-blavoses amb pigments com la clorofil.la o la
ficocianina. Tan sols respiren durant la nit. És possible que les cčl.lules
s'agrupin per formar pseudocolňnies. Es multipliquen per bipartició simple. Un
exemple de cianobacteri és el nňstoc. En trobam
tant a les aigües dolces com a totes les mars del món.
Els cianňfits, també s'anomenen algues blaves o
cianobacteris, encara que el seu color no és sempre el blau. Són procariotes i
fotosintčtics. Actualment són un grup poc conegut, perň la seva importŕncia rau
en el fet que siguin fotosintčtics, ja que sembla que la composició de la
nostra atmosfera, amb gairebé un 21% d'oxigen, és deguda en gran part a la seva
acció durant milions d'anys. En podem trobar a llocs humits, com
ara basses, pous, fonts, i fins i tot a la mar. Alguns cianňfits són capaços de
viure a fonts termals, a temperatures que pocs éssers vius més poden suportar.
|
|